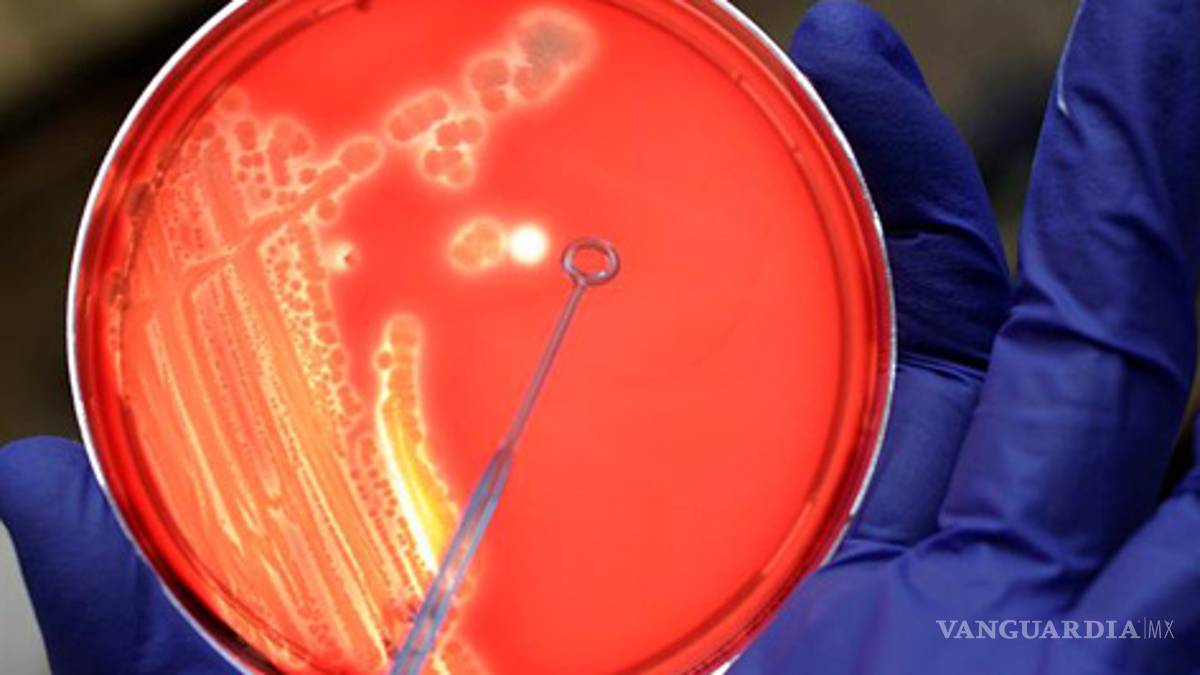

Entérate ¿Qué es la bacteria E. Coli?
COMPARTIR
La bacteria hallada en pepinos españoles es una cepa que produce una potente toxina que puede ocasionar diarreas graves, insuficiencia renal y, en el peor de los casos, la muerte
Ciudad de México. La bacteria de Escherichia coli (E. Coli) normalmente vive en el intestino del hombre y de los animales sin causar ningún tipo problema. Sin embargo algunas cepas debido al intercambio genético son capaces de causar infecciones y provocar diarrea. Cerca del 8% de los casos de E. coli producen el síndrome hemolítico urémico (HUS por sus siglas en inglés).
Las cepas más peligrosas de las bacterias Eschericia choli provocan, además de diarreas graves, insuficiencia renal y, en el peor de los casos, la muerte.
La cepa en Alemania que afectado a más de mil personas es identificada como 0157:H7 de Escherichia coli fue detectada en Baja Sajonia y se ha extendido de norte a sur en más de seis estados alemanes, desde Hamburgo hasta el Sarre.
En los animales estas bacterias se hallan en el intestino de vacas, ovejas, cabras y puede ser transmitidas a través de la leche o la carne. También pueden ser transportados en el abono que se utiliza para el campo, contaminando así la verdura y la fruta.
¿Cómo se contagia?
La falta de higiene en una persona infectada puede transmitir las bacterias. En los niños la transmisión del E. coli es más peligrosa por el contacto que pueden tener con humanos, frutas o carne contaminada sin ningún cuidado.
Los síntomas
Uno de los primeros síntomas son la diarrea, que a pocos días se convierte en hemorrágica. Produce fuertes dolores abdominales que puede confundirse con la apendicitis. La diarrea provocada por la bacteria puede durar de 4 a 5 días, si no es controlada puede producir anemia e insuficiencia renal.
¿Cómo evitar el contagio?
El lavarse las manos, lavar frutas y verduras antes de su consumo es esencial. La higiene personal es básica que la bacteria no se propague como lavarse las manos después de ir al baño así como antes de comer.
Se recomienda lavar los utensilios de cocina con los que se corte fruta verduras y carnes. Es necesario que antes de que se consuman los alimentos se cuezan durante 10 minutos a 70 grados centígrados para que las bacterias mueran.
¿Puede ser mortal?
Algunos casos de E. coli producen el síndrome hemolítico urémico (HUS por sus siglas en inglés). Se estima que hasta un 10% de los pacientes con infección de E. coli pueden desarrollar síndrome urémico hemolítico, con una tasa de fatalidad de casos que van desde 3 a 5%.
¿Existe cura?
No existe una cura específica, el tratamiento con antibióticos que se usa no es eficaz. En algunas situaciones el uso de medicamentos puede ver empeorar la enfermedad ya que aumentan, ya que aumente la liberación de toxinas que produce la bacteria.
Se trata a través de la rehidratación por la diarrea y diálisis para reducir el daño renal.
(Con información de la OMS y la ABC.es)
